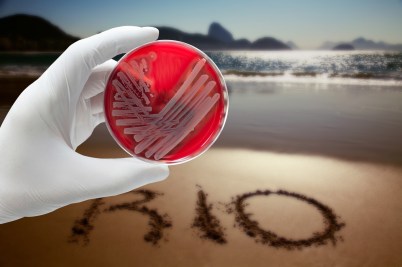

Daniel
Faber
Professor of Sociology, Director of the Northeastern Environmental Justice Research Collaborative
Daniel Faber in the Press
GBH
Why loose trash covers some Worcester streets, but not others
Daniel Faber, director of the Environmental Justice Research Collaborative at Northeastern University, said this is a major equity problem with pay-as-you-throw systems. Like a regressive tax, he said, Worcester’s trash program may appear to treat everyone equally, but it’s actually unfair because in more affluent areas, residents can afford the yellow bags. In lower-income communities, by […]
Rhode Island Public Radio
‘Hit first and worst’: Region’s communities of color brace for climate change impacts
Daniel Faber is the director of the Northeastern University Environmental Justice Research Collaborative. With projected sea level rises for the area of anywhere between six and 15 feet, Faber says the risk for catastrophic failures at sites like Chelsea’s fuel storage tanks are high.
WNPR
How one Massachusetts city came to bear environmental burdens for the region
Daniel Faber is director of the Northeastern University Environmental Justice Research Collaborative. He’s crunched some numbers and according to his findings,Chelsea is one of the most environmentally overburdened places in the state. “Communities that lack the political, economic power to defend themselves, where residents work longer hours, and they have less resources and are less educated, […]
‘Hit first and worst’: Region’s communities of color brace for climate change impacts
Daniel Faber is the director of the Northeastern University Environmental Justice Research Collaborative. With projected sea level rises for the area of anywhere between six and 15 feet, Faber says the risk for catastrophic failures at sites like Chelsea’s fuel storage tanks are high. “You’re looking at the flooding of some very significant areas of Chelsea and Boston, […]
The Christian Science Monitor
Small town tries to put lid on power of big trash
Private waste companies are looking to be “economically efficient and politically expedient,” says Daniel Faber, director of Northeastern University’s Environmental Justice Research Collaborative (NEJRC) in Boston. This means choosing host communities with lower education levels and less time, money, and resources to mobilize themselves, he says. “They are less likely to offer opposition.”
WCAI
Climate change is hitting home, and it’s not fair
In fact, while Massachusetts is known for its ambitious environmental policies, Daniel Faber, an environmental justice researcher at Northeastern University and director of the Northeastern Environmental Justice Research Collaborative, has found that the Commonwealth has some of the most dramatic inequities of any state in the U.S. Communities of color bear twenty times the environmental […]
Worcester Telegram
Unhealthy air days common in Mass. despite progress
“We clearly need to make this move and transition away from our dependence upon fuels from hell – coal, oil and gas – to a new economy based upon fuels from heaven, solar and wind in particular,” said Northeastern University professor Daniel Faber, director of the Northeastern Environmental Justice Research Collaborative.
Boston Herald
Hundreds protest ‘attack on science’
“The attack on science, particularly climate science, poses an existential threat to human civilization as we know it,” said Daniel Faber, director of the Northeastern Environmental Justice Research Collaborative. “Denying science is a declaration of war on current and future generations and it is unacceptable and we are here to stand up and fight for […]
WGBH
Low income communities bear brunt of environmental burden
Slogans of recent movements against police brutality — including “I Can’t Breath” and “Black Lives Matter” — are a testament to the parallels between themes in the movement against policy brutality and those in environmental movements. “I can’t breath has a double meaning; it’s not only about the increased repression that is being expressed in […]
WCAI
Massachusetts has an environmental justice problem
While the high-profile deaths of Michael Brown and Eric Garner at the hands of police have drawn national attention, there’s a more insidious threat facing communities of color across the country – environmental pollution. In recent weeks, some environmentalists have drawn a connection, giving double meaning to slogans like “Black Lives Matter” and “I can’t […]